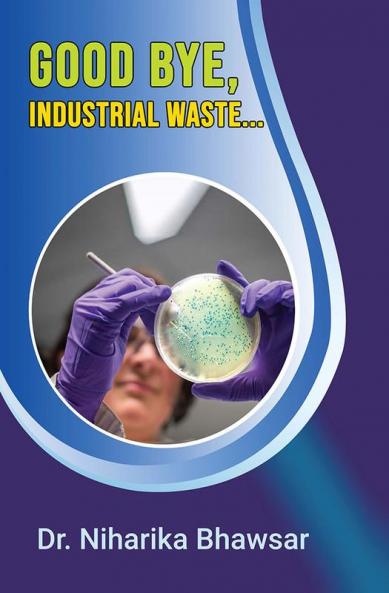

English
Paperback
₹382
₹449
14.92% OFF
(All inclusive*)
Delivery Options
Please enter pincode to check delivery time.
*COD & Shipping Charges may apply on certain items.
Review final details at checkout.
Looking to place a bulk order? SUBMIT DETAILS
Delivery Options
Please enter pincode to check delivery time.
*COD & Shipping Charges may apply on certain items.
Review final details at checkout.
About The Book
Description
Author
NA
Details
ISBN 13
9789395037174
Publication Date
-28-05-2023
Pages
-164
Weight
-232 grams
Dimensions
-152.4x228.6x9.03 mm